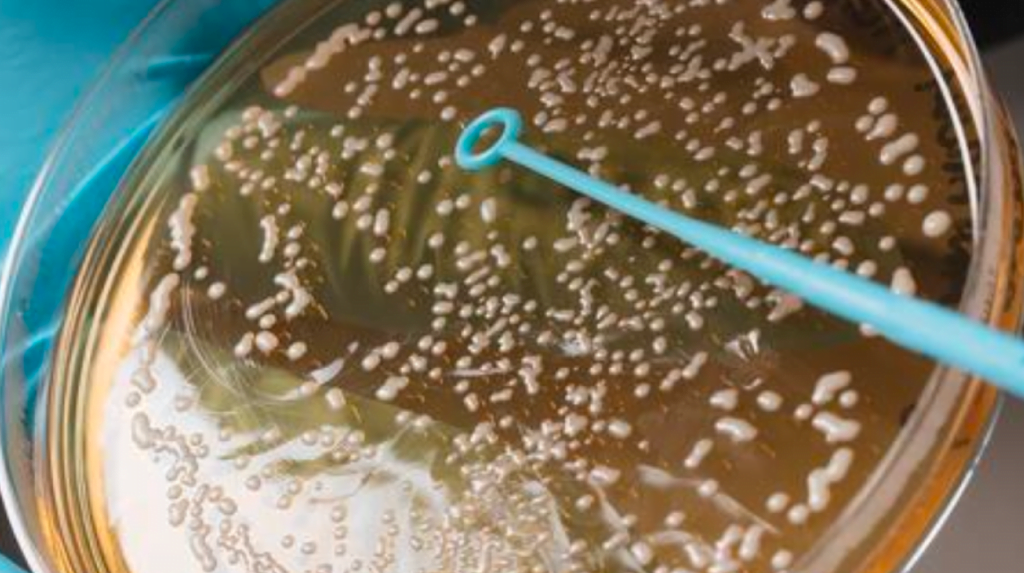
LEVADURAS-NO-SACCHAROMYCES

El empleo de levaduras no-Saccharomyces en vinificación es una estrategia para mejorar la calidad de los vinos que durante la última década se ha puesto muy de moda. Pero, ¿a qué levaduras nos referimos cuando hablamos de no-Saccharomyces? ¿Pueden ayudar a mejorar la calidad de los vinos o son alterantes? ¿Podríamos considerar esta herramienta biotecnológica como la clave de la vinificación del futuro? En este artículo resolvemos estas y muchas otras preguntas. ¡Sigue leyendo!
¿Qué son las levaduras no-Saccharomyces?
Toda levadura que no sea del género Saccharomyces que es la levadura fermentativa por excelencia, puede clasificarse como no-Saccharomyces. A finales del siglo pasado en la década de los 80 y 90 con la aparición de las primeras levaduras secas activas (LSA) para la elaboración de vinos, las levaduras no-Saccharomyces pasaron a ser consideradas como alterantes o indeseadas por una gran mayoría del sector vitivinícola. Las LSA permitían a los elaboradores disponer de mucha más seguridad durante la fermentación alcohólica, cinéticas de fermentación más rápidas, sin ralentizaciones, con muchas menos paradas de fermentación, obtener vinos con valores de acidez volátil más bajos, entre otros.
Beneficios de usar levaduras no-Saccharomyces para mejorar la calidad de los vinos
La realidad es que la enología y la investigación enológica ha seguido avanzando y con el tiempo, se ha visto que el empleo de LSA lleva a vinos mucho más homogéneos y sin tipicidad. Actualmente, se sabe que el empleo de levaduras no-Saccharomyces permite un aporte distintivo al perfil organoléptico de los vinos en comparación con los vinos elaborados únicamente con levaduras Saccharomyces, por este motivo en los últimos años se ha extendido el uso de este género de levaduras. Entre los atributos que permiten moldear las levaduras no-Saccharomyces destacan algunas como la acidez, glicerol, manoproteínas, aromas, color, grado alcohólico, capacidad espumante, entre muchas otras.
Fermentaciones espontáneas con este tipo de biotecnología
En la realización de fermentaciones espontáneas, se observa como hay una gran variabilidad de cepas de levadura, Saccharomyces y no-Saccharomyces. Las no-Saccharomyces, que son las que predominan en la uva, se imponen en las primeras fases de la fermentación alcohólica y a medida que ésta avanza, van disminuyendo su presencia en favor de las Saccharomyces que terminan imponiéndose y llevando a cabo la fermentación alcohólica hasta el final.
En la siguiente Figura se representa la biodiversidad de especies y cepas de levadura aisladas en uva. Se observa como hay una gran diversidad de levaduras y donde predominan las especies no-Saccharomyces. Es precisamente esta biodiversidad la que permite obtener vinos lo más auténticos y representativos posibles del terroir donde son elaborados.

Métodos de empleo de este tipo de levaduras
Actualmente, el empleo de levaduras no-Saccharomyces en vinificación puede darse por diferentes planteamientos.
- El primero por realización de fermentaciones espontáneas, y por tanto, presencia de múltiples levaduras autóctonas con los riesgos que puede conllevar.
- Segundo mediante la preparación de pie de cuba de forma artesanal o bien con uso de Bioreactores.
- Y finalmente, mediante la inoculación directa de levaduras no-Saccahromyces seleccionadas por sus interesantes propiedades.
En este último caso, y transcurrido un tiempo, siempre será necesario inocular una levadura Saccharomyces para terminar la fermentación alcohólica.
Tres levaduras no-Saccharomyces recomendadas
A continuación, os detallamos tres levaduras no-Saccharomyces de LEV2050 interesantes por sus propiedades ya sea para el incremento de acidez o por el aporte de complejidad organoléptica.
Levadura K-ACID, Lachancea thermotolerans, pensada para la acidificación
Con el cambio climático cada vendimia es más difícil conseguir una buena maduración fenólica y tecnológica a la vez, y la gran perjudicada es la acidez de las uvas y mostos. La levadura K-ACID es una levadura no-Saccharomyces Lachancea thermotolerans diseñada para la acidificación de mostos e incremento de la frescura de los vinos de forma natural mediante la producción de ácido láctico.
- Permite reducciones de pH de hasta 0.9 puntos
- Genera hasta 12 g/L de ácido láctico
- Potencia el perfil aromático y mejora la tonalidad
Su uso está pensado para utilizarse sobre la totalidad del mosto siguiendo la evolución del pH hasta el valor deseado con una inoculación posterior de la levadura fermentativa o bien para la acidificación total de un mosto y posterior mezcla con los mostos a acidificar. Para lograr el equilibrio perfecto se recomienda utilizar K-ACID en porcentajes bajos según el perfil del vino deseado (entre un 3 y 8 % de la mezcla acidificada).
Debaryomyces hansenii (54) en crema, pensada para la vinificación de blancos
Si el objetivo es elaborar vinos blancos frescos, minerales y con buena amplitud en boca, ésta es la levadura indicada para las primeras 24h. Levadura no-Saccharomyces Debaryomyces hansenii en estado crema. Permite un aporte distintivo al perfil organoléptico de los vinos en comparación con los vinos elaborados únicamente con levaduras Saccharomyces, puede inocularse directamente en el depósito una vez atemperada y activada y se recomienda a las 16-24h inocular la levadura Saccharomyces deseada para el desarrollo de la fermentación alcohólica.
Pichia kluyveri (79) en crema, herramienta de Bioprotección
La Bioprotección en enología consiste en la aplicación de microorganismos al mosto con el único objetivo de colonizar el medio y evitar así el desarrollo de microorganismos alterantes ejerciendo un efecto antiséptico. Esta técnica está especialmente indicada para la elaboración de vinos sin sulfuroso. Nuestra propuesta de Pichia kluyveri además, presenta una muy fácil aplicación ya sea con aplicación directa o crecimiento en Biorreactor ya que se trata de una levadura activa en suspensión.
Estas son algunas de nuestras propuestas de cómo el uso de levaduras no-Saccharomyces permiten incrementar la acidez de forma natural y elaborar vinos singulares y de propiedades organolépticas atractivas para los consumidores de hoy en día, pero no son las únicas. Para más información contacta con nosotros o consulta nuestros servicios en nuestra página web.